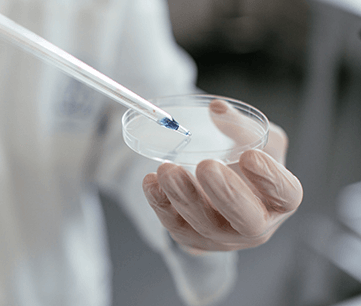
sk바이오팜 주가

-
sk바이오팜 주가 분석 및 전망 목표가주식정보 2024. 8. 28. 13:25
2024년 8월 현재, SK바이오팜 주가는 최근 몇 달간 변동성을 보여주고 있습니다. 현재 주가는 108,200원 수준에서 거래되고 있으며, 최근 주가 목표치는 105,308원으로 상향 조정되었습니다. 이는 전년 대비 약 9.2% 상승한 수치로, 분석가들이 향후 성장 가능성을 긍정적으로 평가하고 있음을 나타냅니다.

전고체 배터리 관련주 BEST 12
전고체 배터리 기술이 전기차 시장에서 주목받고 있는 가운데, 관련주들이 큰 관심을 받고 있습니다. 전고체 배터리는 기존 리튬이온 배터리보다 안전성과 효율성이 뛰어나며, 특히 전기차의
koreasmokingarea.jeong-kim.com
주요 요인 분석
- 실적 개선: SK 바이오팜의 매출은 전년도에 비해 증가하고 있습니다. 2023년 매출은 약 3548억 원으로, 2022년 대비 44.16% 증가했습니다. 이는 신약 개발과 글로벌 시장 진출 확대로 인한 매출 성장으로 평가됩니다.
- 연구 개발(R&D) 강화: SK 바이오팜은 연구 개발에 지속적으로 투자하고 있으며, 특히 신경계 질환 치료제 개발에 주력하고 있습니다. 이러한 R&D 투자로 인해 장기적으로 기업 가치를 높일 수 있을 것으로 기대됩니다.
- 재무 건전성: 회사의 재무 상태는 안정적입니다. SK 바이오팜은 부채를 줄이고 있으며, 2024년에도 재무 구조 개선이 지속될 것으로 보입니다. 이는 투자자들에게 긍정적인 신호로 작용할 수 있습니다.SK 바이오팜의 재무 상태는 비교적 안정적이며, R&D 투자와 신약 개발로 인한 매출 증대가 예상됩니다. 현재 분석가들은 SK 바이오팜의 2024년 목표 sk바이오팜 주가를 110,000원에서 120,000원 사이로 전망하고 있습니다.
신약 개발 진행 상황
SK바이오팜 주가는 최근 다양한 신약 개발 프로젝트를 통해 주목받고 있습니다. 특히, FL-091이라는 방사성 의약품을 개발하여 다수의 고형 종양을 타겟으로 하는 혁신적인 항암 치료제를 개발 중입니다. 이 프로젝트는 Full-Life Technologies와의 라이선스 계약을 통해 진행되고 있으며, 총 5억 7천만 달러 규모의 계약으로, 글로벌 시장에서의 상용화를 목표로 하고 있습니다. 이러한 신약 개발은 SK 바이오팜의 주가에 긍정적인 영향을 미칠 것으로 예상됩니다.
또한, SK 바이오팜은 신경계 질환 치료제 개발에서도 두각을 나타내고 있으며, Proteovant Therapeutics와의 협력을 통해 단백질 분해제를 활용한 신약 개발에도 박차를 가하고 있습니다. 이러한 신약 개발 노력은 장기적으로 회사의 수익성과 sk바이오팜 주가에 긍정적인 영향을 줄 것으로 보입니다.


삼성바이오로직스 주가 분석 및 전망 목표가
삼성바이오로직스는 2011년에 설립된 글로벌 바이오의약품 제조 및 개발 서비스 제공업체로, 한국 코스피 시장에서 주요 종목 중 하나입니다. 주요 매출은 CDMO(Contract Development and Manufacturing Organiz
koreasmokingarea.jeong-kim.com
전망 및 목표가
2024년 하반기에는 신약 출시 및 글로벌 시장에서의 확장에 따라 매출 성장이 예상됩니다. 이에 따라 sk바이오팜 주가 역시 추가 상승 가능성이 있습니다. 다만, 단기적인 시장 변동성과 제약산업 특유의 불확실성은 고려해야 할 요소입니다. 현재 분석가들은 SK 바이오팜의 2024년 목표 주가를 약 110,000원에서 120,000원 사이로 제시하고 있으며, 이는 시장에서의 긍정적인 전망을 반영한 것입니다.


중동 전쟁 관련주 BEST 18
중동 전쟁과 관련된 최신 관련주들에 대해 분석해보면, 최근의 지정학적 긴장 속에서 주목받고 있는 여러 주식들이 있습니다. 이 글에서는 중동 전쟁 관련주 국내 주식과 미국 주식을 포함하여
koreasmokingarea.jeong-kim.com
SK바이오팜 주가 변동 가능성은 어떻게 될까?
SK 바이오팜은 현재 다양한 신약 개발 프로젝트를 진행 중이며, 특히 방사성 의약품 FL-091의 개발이 주목받고 있습니다. 이와 함께 Proteovant Therapeutics와의 협력을 통해 신경계 질환 및 단백질 분해제를 활용한 치료제를 개발하고 있습니다. 이러한 혁신적인 신약 개발은 SK 바이오팜의 주가에 긍정적인 영향을 미칠 가능성이 큽니다


타이거차이나전기차 주가 분석 및 전망 목표가
타이거 차이나 전기차 ETF는 중국 전기차 시장의 대표적인 기업들(BYD, NIO, XPeng, Li Auto 등)에 투자하는 상품으로, 2021년 11월 약 20,725 포인트로 최고점을 기록한 후, 현재 약 6,240 포인트로 하락한 상
koreasmokingarea.jeong-kim.com
이 글을 마무리 하며
SK바이오팜 주가는 지속적인 연구 개발과 글로벌 시장 확대를 통해 성장 가능성이 높은 기업입니다. 그러나 제약 산업의 특성상 불확실성이 존재하므로, 장기적인 투자 관점에서 접근하는 것이 바람직합니다.




sk바이오팜 주가 '주식정보' 카테고리의 다른 글
럼피스킨병 관련주 BEST 12 (0) 2024.09.02 엠폭스관련주 BEST 19 추천 (0) 2024.09.02 딥페이크 관련주 BEST 10 (0) 2024.08.27 중동 전쟁 관련주 BEST 18 (0) 2024.08.26 9월 금리 인하 수혜주 BEST 12 (0) 2024.08.25